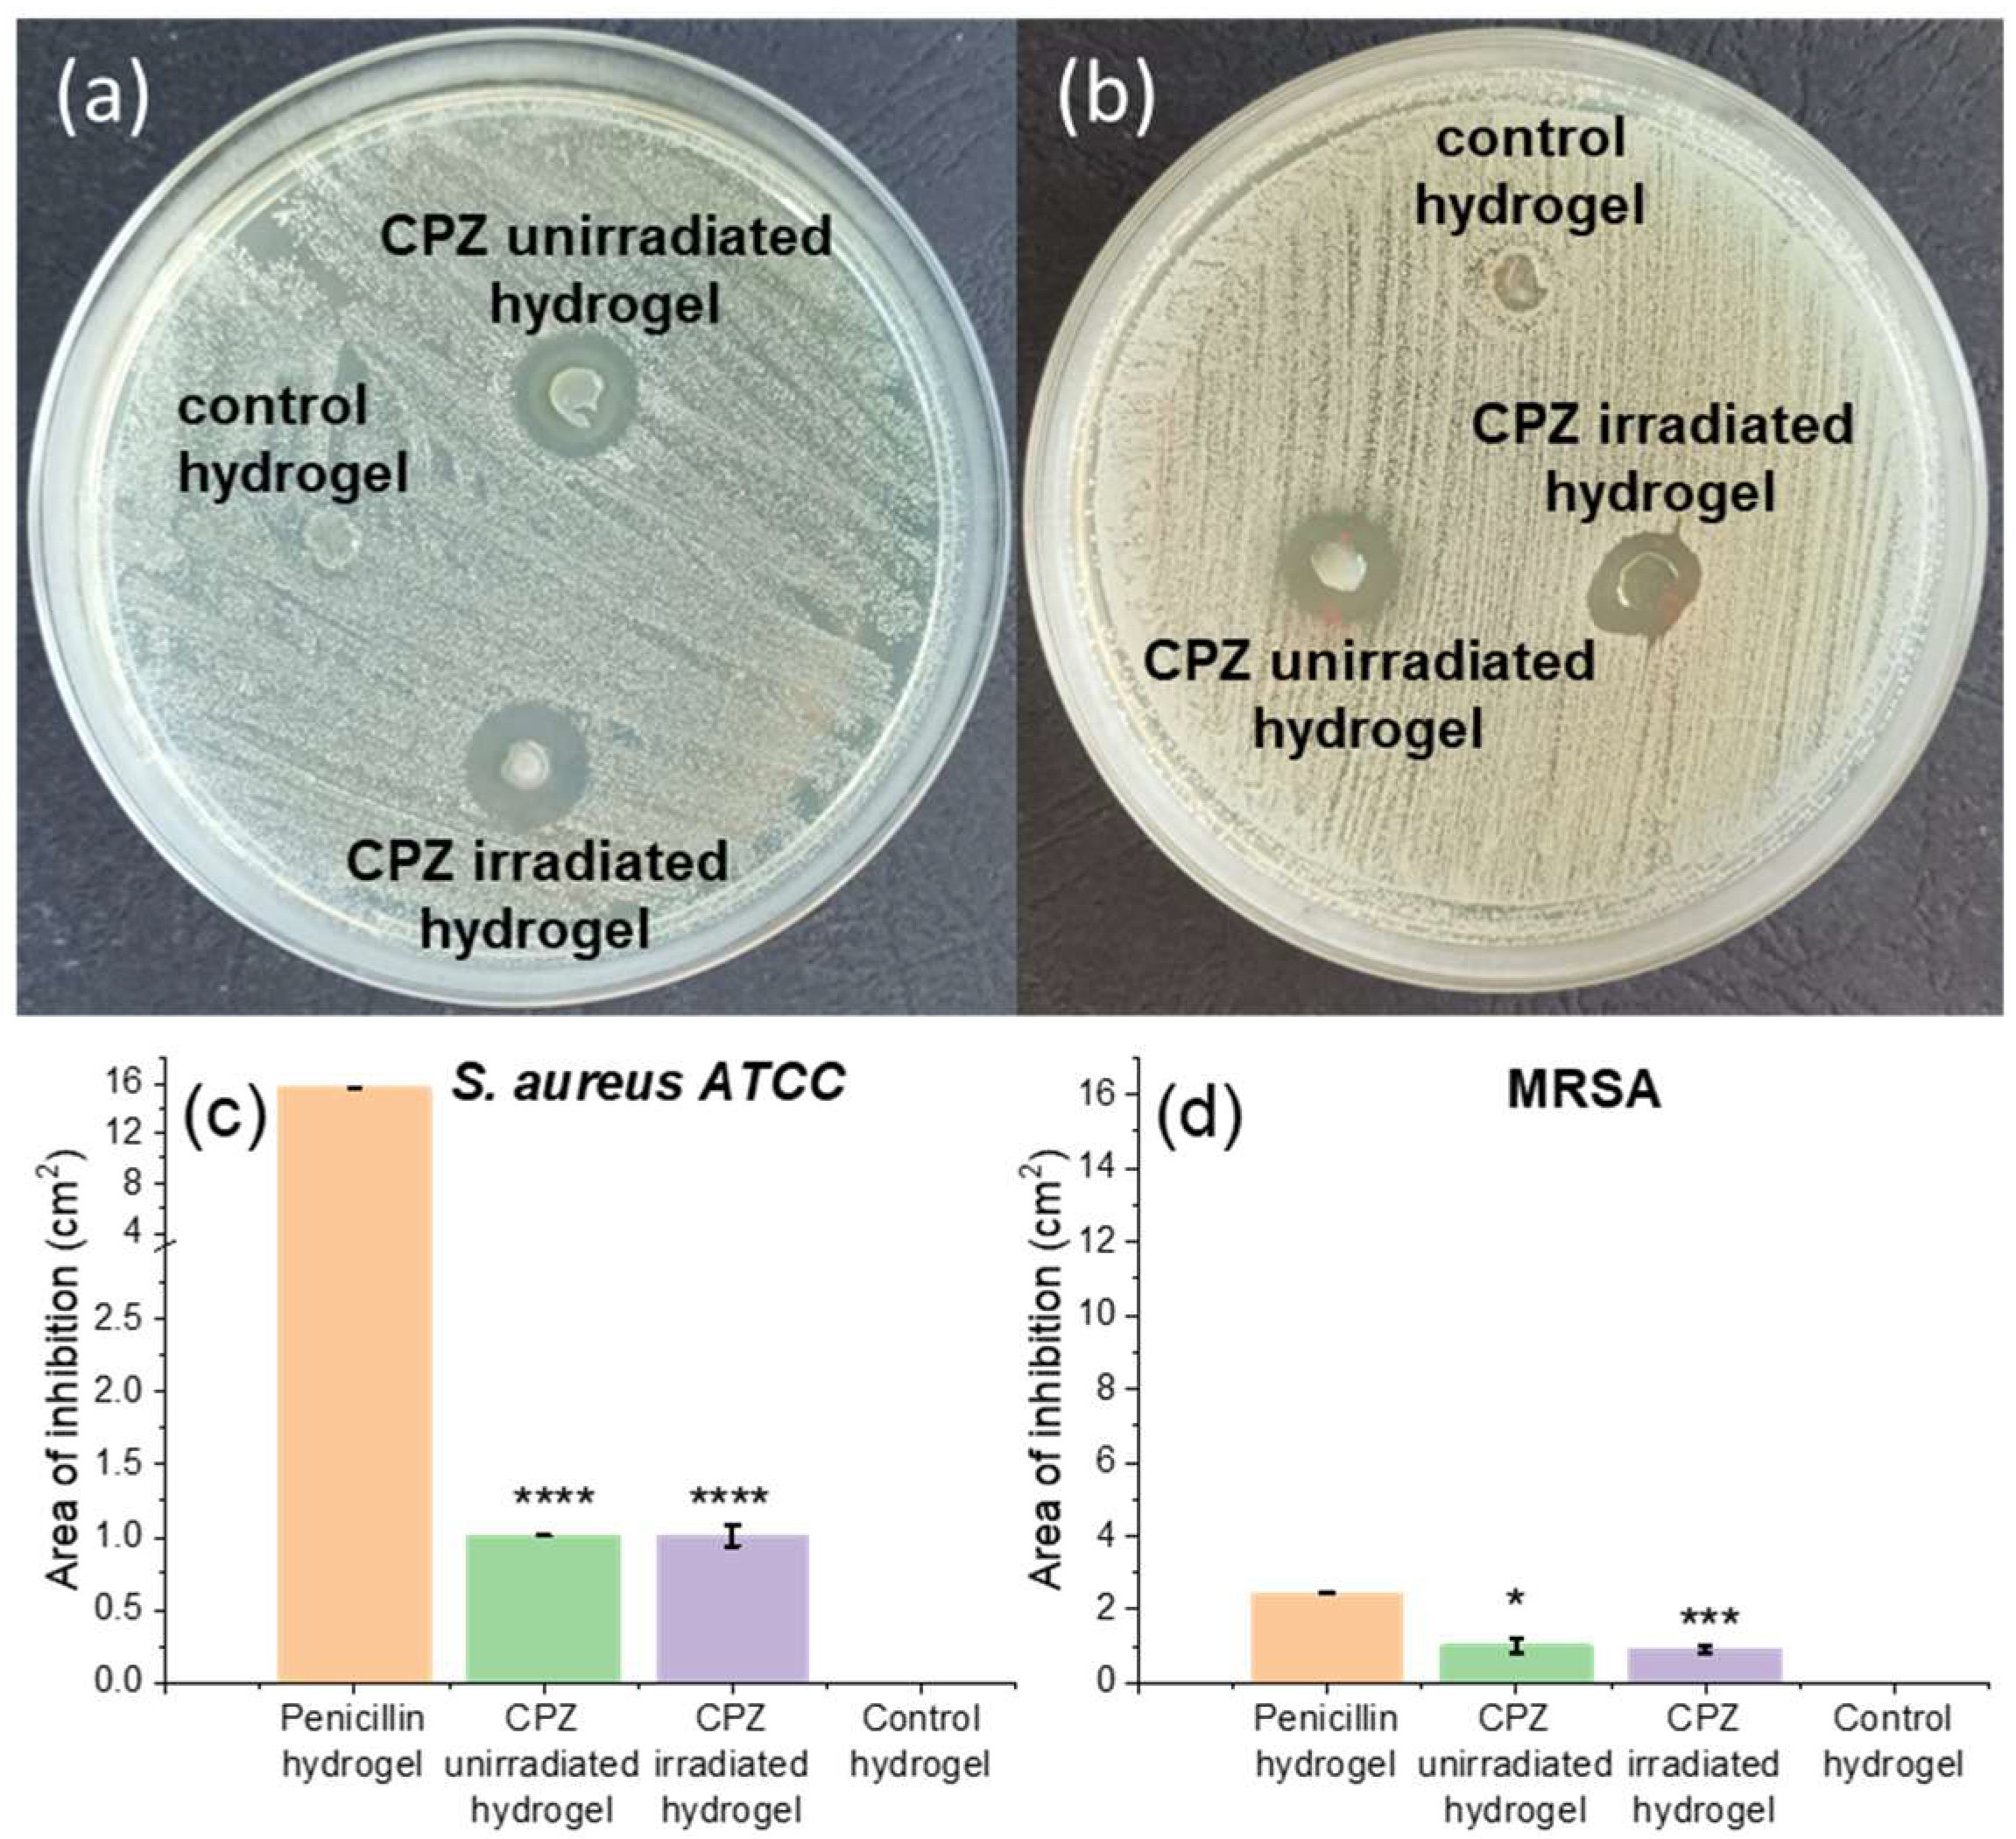

Pulsed Laser Photo-Crosslinking of Gelatin Methacryloyl Hydrogels for the Controlled Delivery of Chlorpromazine to Combat Antimicrobial Resistance
Abstract
1. Introduction
2. Materials and Methods
2.1. Materials
2.2. Hydrogel Photo-Crosslinking
2.3. Hydrogel Characterization
2.4. Theoretical Absorption Spectra of Photoinitiator Simulations
2.5. In Vitro Biological Evaluation
2.5.1. Antimicrobial Assays
2.5.2. Cell Viability and Morphology Assays
3. Results and Discussion
3.1. Hydrogel Synthesys
3.2. The Effect of Irradiation Time and Energy on the Photo-Crosslinking of the GelMa Hydrogels
3.2.1. Unreacted Irgacure after Photo-Polymerization of GelMa Hydrogels Analysis
3.2.2. Swelling Behavior of GelMa Hydrogels
3.2.3. In Vitro Release of CPZ from the GelMa Hydrogels
3.3. Characterization of the GelMa Hydrogels Resulting when 0.75 mJ Beam Energy and 1 min Exposure Time Were Used
3.3.1. Laser-Induced Fluorescence and Fluorescence Kinetics Profile Assay
3.3.2. FTIR Spectroscopy
3.3.3. UV-Vis Sbsorption Spectroscopy
3.3.4. SEM Snalysis
3.4. In Vitro Biological Evaluation of Unirradiated and Irradiated CPZ-Loaded GelMa Hydrogels
3.4.1. Disc Diffusion Sensitivity Assay of Loaded Hydrogels against S. aureus and MRSA
3.4.2. Bacterial Adherence to Loaded GelMa Hydrogels Assay
3.4.3. In Vitro Evaluation of L929 Cells’ Viability and Morphology
4. Conclusions
Author Contributions
Funding
Institutional Review Board Statement
Informed Consent Statement
Data Availability Statement
Conflicts of Interest
References
- Cohen, J. Clinical trials: IL-12 deaths: Explanation and a puzzle. Science 1995, 270, 908. [Google Scholar] [CrossRef] [PubMed]
- Florence, A.T.; Jani, P.U. Novel oral drug formulations: Their potential in modulating adverse effects. Drug Saf. 1994, 10, 233–266. [Google Scholar] [CrossRef] [PubMed]
- Roy, R.; Tiwari, M.; Donelli, G.; Tiwari, V. Strategies for combating bacterial biofilms: A focus on anti-biofilm agents and their mechanisms of action. Virulence 2018, 9, 522–554. [Google Scholar] [CrossRef] [PubMed]
- Arjama, M.; Mehnath, S.; Rajan, M.; Jeyaraj, M. Sericin/RBA embedded gellan gum based smart nanosystem for PH responsive drug delivery. Int. J. Biol. Macromol. 2018, 120, 1561–1571. [Google Scholar] [CrossRef]
- Mehnath, S.; Chitra, K.; Karthikeyan, K.; Jeyaraj, M. Localized delivery of active targeting micelles from nanofibers patch for effective breast cancer therapy. Int. J. Pharm. 2020, 584, 119412. [Google Scholar] [CrossRef] [PubMed]
- Hussain, K.; Aslam, Z.; Ullah, S.; Shah, M.R. Synthesis of PH responsive, photocrosslinked gelatin-based hydrogel system for control release of ceftriaxone. Chem. Phys. Lipids 2021, 238, 105101. [Google Scholar] [CrossRef] [PubMed]
- Ribeiro, J.S.; Sanz, C.K.; Münchow, E.A.; Kalra, N.; Dubey, N.; Suárez, C.E.C.; Fenno, J.C.; Lund, R.G.; Bottino, M.C. Photocrosslinkable methacrylated gelatin hydrogel as a cell-friendly injectable delivery system for chlorhexidine in regenerative endodontics. Dent. Mater. 2022, 38, 1507–1517. [Google Scholar] [CrossRef]
- Walter, J.R.; Xu, S. Therapeutic transdermal drug innovation from 2000 to 2014: Current status and outlook. Drug Discov. Today 2015, 20, 1293–1299. [Google Scholar] [CrossRef]
- Prausnitz, M.R.; Langer, R. Transdermal drug delivery. Nat. Biotechnol. 2008, 26, 1261–1268. [Google Scholar] [CrossRef]
- Almoshari, Y. Novel hydrogels for topical applications: An updated comprehensive review based on source. Gels 2022, 8, 174. [Google Scholar] [CrossRef]
- Lim, H.W.; Collins, S.A.B.; Resneck, J.S.; Bolognia, J.L.; Hodge, J.A.; Rohrer, T.A.; Van Beek, M.J.; Margolis, D.J.; Sober, A.J.; Weinstock, M.A.; et al. The burden of skin disease in the United States. J. Am. Acad. Dermatol. 2017, 76, 958–972.e2. [Google Scholar] [CrossRef]
- Dawson, A.L.; Dellavalle, R.P.; Elston, D.M. Infectious skin diseases: A review and needs assessment. Dermatol. Clin. 2012, 30, 141–151. [Google Scholar] [CrossRef]
- Dannaker, C. Waterborne Topical Compositions for the Delivery of Azelaic Acid for Treatment of Skin Conditions Such as Acne Vulgaris, Rosacea Seborrheic Dermatitis. U.S. Patent Application 14/283,073, 30 April 2015. [Google Scholar]
- Xia, Z.; Marsh, A. Topical Drug Patch Including Microspheres. U.S. Patent Application 14/913,540, 21 August 2013. [Google Scholar]
- Sachdeva, M.S.; Patlolla, R. Nanoparticle Formulations for Skin Delivery. U.S. Patent Application 12/433,344, 30 April 2009. [Google Scholar]
- Zhang, Y.; Hansen, K.J.; Determan, A.S. Microneedle Devices and Methods. AU Patent 2012225608A, 6 March 2012. [Google Scholar]
- Narayanaswamy, R.; Torchilin, V.P. Hydrogels and their applications in targeted drug delivery. Molecules 2019, 24, 603. [Google Scholar] [CrossRef]
- Gupta, B.; Agarwal, R.; Alam, M.S. Hydrogels for wound healing applications. In Biomedical Hydrogels; Woodhead Publishing: Sawston, UK, 2011; pp. 184–227. ISBN 978-1-84569-590-3. [Google Scholar]
- Li, J.; Mooney, D.J. Designing hydrogels for controlled drug delivery. Nat. Rev. Mater. 2016, 1, 16071. [Google Scholar] [CrossRef] [PubMed]
- Almeida, J.F.; Ferreira, P.; Lopes, A.; Gil, M.H. Photocrosslinkable biodegradable responsive hydrogels as drug delivery systems. Int. J. Biol. Macromol. 2011, 49, 948–954. [Google Scholar] [CrossRef]
- Kamoun, E.A.; Winkel, A.; Eisenburger, M.; Menzel, H. Carboxylated camphorquinone as visible-light photoinitiator for biomedical application: Synthesis, characterization, and application. Arab. J. Chem. 2016, 9, 745–754. [Google Scholar] [CrossRef]
- Burke, G.; Cao, Z.; Devine, D.M.; Major, I. Preparation of biodegradable polyethylene glycol dimethacrylate hydrogels via thiol-ene chemistry. Polymers 2019, 11, 1339. [Google Scholar] [CrossRef] [PubMed]
- Sabnis, A.; Rahimi, M.; Chapman, C.; Nguyen, K.T. Cytocompatibility studies of an in situ photopolymerized thermoresponsive hydrogel nanoparticle system using human aortic smooth muscle cells. J. Biomed. Mater. Res. 2009, 91A, 52–59. [Google Scholar] [CrossRef]
- Nichol, J.W.; Koshy, S.T.; Bae, H.; Hwang, C.M.; Yamanlar, S.; Khademhosseini, A. Cell-laden microengineered gelatin methacrylate hydrogels. Biomaterials 2010, 31, 5536–5544. [Google Scholar] [CrossRef] [PubMed]
- Loessner, D.; Meinert, C.; Kaemmerer, E.; Martine, L.C.; Yue, K.; Levett, P.A.; Klein, T.J.; Melchels, F.P.W.; Khademhosseini, A.; Hutmacher, D.W. Functionalization, preparation and use of cell-laden gelatin methacryloyl—Based hydrogels as modular tissue culture platforms. Nat. Protoc. 2016, 11, 727–746. [Google Scholar] [CrossRef]
- Tomal, W.; Ortyl, J. Water-soluble photoinitiators in biomedical applications. Polymers 2020, 12, 1073. [Google Scholar] [CrossRef] [PubMed]
- Zhang, Y.S.; Davoudi, F.; Walch, P.; Manbachi, A.; Luo, X.; Dell’Erba, V.; Miri, A.K.; Albadawi, H.; Arneri, A.; Li, X.; et al. Bioprinted thrombosis-on-a-chip. Lab Chip 2016, 16, 4097–4105. [Google Scholar] [CrossRef]
- Assmann, A.; Vegh, A.; Ghasemi-Rad, M.; Bagherifard, S.; Cheng, G.; Sani, E.S.; Ruiz-Esparza, G.U.; Noshadi, I.; Lassaletta, A.D.; Gangadharan, S.; et al. A highly adhesive and naturally derived sealant. Biomaterials 2017, 140, 115–127. [Google Scholar] [CrossRef]
- Williams, C.G.; Malik, A.N.; Kim, T.K.; Manson, P.N.; Elisseeff, J.H. Variable cytocompatibility of six cell lines with photoinitiators used for polymerizing hydrogels and cell encapsulation. Biomaterials 2005, 26, 1211–1218. [Google Scholar] [CrossRef]
- Denmark, D.J.; Hyde, R.H.; Gladney, C.; Phan, M.-H.; Bisht, K.S.; Srikanth, H.; Mukherjee, P.; Witanachchi, S. Photopolymerization-based synthesis of iron oxide nanoparticle embedded PNIPAM nanogels for biomedical applications. Drug Deliv. 2017, 24, 1317–1324. [Google Scholar] [CrossRef]
- Qin, X.-H.; Ovsianikov, A.; Stampfl, J.; Liska, R. Additive manufacturing of photosensitive hydrogels for tissue engineering applications. BioNanoMaterials 2014, 15, 49–70. [Google Scholar] [CrossRef]
- Klotz, B.J.; Gawlitta, D.; Rosenberg, A.J.W.P.; Malda, J.; Melchels, F.P.W. Gelatin-methacryloyl hydrogels: Towards biofabrication-based tissue repair. Trends Biotechnol. 2016, 34, 394–407. [Google Scholar] [CrossRef]
- O’Connell, C.D.; Zhang, B.; Onofrillo, C.; Duchi, S.; Blanchard, R.; Quigley, A.; Bourke, J.; Gambhir, S.; Kapsa, R.; Di Bella, C.; et al. Tailoring the mechanical properties of gelatin methacryloyl hydrogels through manipulation of the photocrosslinking conditions. Soft Matter 2018, 14, 2142–2151. [Google Scholar] [CrossRef]
- Billiet, T.; Gevaert, E.; De Schryver, T.; Cornelissen, M.; Dubruel, P. The 3D printing of gelatin methacrylamide cell-laden tissue-engineered constructs with high cell viability. Biomaterials 2014, 35, 49–62. [Google Scholar] [CrossRef]
- Ouyang, L.; Highley, C.B.; Sun, W.; Burdick, J.A. A Generalizable strategy for the 3D bioprinting of hydrogels from nonviscous photo-crosslinkable inks. Adv. Mater. 2017, 29, 1604983. [Google Scholar] [CrossRef]
- Vigata, M.; Meinert, C.; Pahoff, S.; Bock, N.; Hutmacher, D.W. Gelatin methacryloyl hydrogels control the localized delivery of albumin-bound paclitaxel. Polymers 2020, 12, 501. [Google Scholar] [CrossRef] [PubMed]
- Zhu, M.; Wang, Y.; Ferracci, G.; Zheng, J.; Cho, N.-J.; Lee, B.H. Gelatin methacryloyl and its hydrogels with an exceptional degree of controllability and batch-to-batch consistency. Sci. Rep. 2019, 9, 6863. [Google Scholar] [CrossRef]
- Alexandru, T.; Staicu, A.; Pascu, A.; Radu, E.; Stoicu, A.; Nastasa, V.; Dinache, A.; Boni, M.; Amaral, L.; Pascu, M.L. Characterization of mixtures of compounds produced in chlorpromazine aqueous solutions by ultraviolet laser irradiation: Their applications in antimicrobial assays. J. Biomed. Opt. 2014, 20, 051002. [Google Scholar] [CrossRef] [PubMed]
- Alexandru, T.; Armada, A.; Danko, B.; Hunyadi, A.; Militaru, A.; Boni, M.; Nastasa, V.; Martins, A.; Viveiros, M.; Pascu, M.; et al. Biological evaluation of products formed from the irradiation of chlorpromazine with a 266 nm laser beam. Biochem. Pharmacol. 2013, 2, 1000109. [Google Scholar] [CrossRef]
- Armada, A.M.; Alexandru, T.; Machado, D.; Danko, B.; Hunyadi, A.; Dinache, A.; Nastasa, V.; Boni, M.; Ramos, J.; Viveiros, M.; et al. The in vitro activity of products formed from exposure of chlorpromazine to a 266 nm laser beam against species of mycobacteria of human interest. In Vivo 2013, 27, 605–610. [Google Scholar]
- Tozar, T.; Nastasa, V.; Stoicu, A.; Chifiriuc, M.C.; Popa, M.; Kamerzan, C.; Pascu, M.L. In vitro antimicrobial efficacy of laser exposed chlorpromazine against gram-positive bacteria in planktonic and biofilm growth state. Microb. Pathog. 2019, 129, 250–256. [Google Scholar] [CrossRef]
- Nistorescu, S.; Gradisteanu Pircalabioru, G.; Udrea, A.-M.; Simon, A.; Pascu, M.L.; Chifiriuc, M.-C. Laser-irradiated chlorpromazine as a potent anti-biofilm agent for coating of biomedical devices. Coatings 2020, 10, 1230. [Google Scholar] [CrossRef]
- Giudice, P. Skin infections caused by staphylococcus aureus. Acta Derm. Venerol. 2020, 100, 208–215. [Google Scholar] [CrossRef]
- Montgomery, C.P.; David, M.Z.; Daum, R.S. Host factors that contribute to recurrent staphylococcal skin infection. Curr. Opin. Infect. Dis. 2015, 28, 253–258. [Google Scholar] [CrossRef]
- Nagasawa, N.; Yagi, T.; Kume, T.; Yoshii, F. Radiation crosslinking of carboxymethyl starch. Carbohydr. Polym. 2004, 58, 109–113. [Google Scholar] [CrossRef]
- Spiller, K.L.; Laurencin, S.J.; Lowman, A.M. Characterization of the behavior of porous hydrogels in model osmotically-conditioned articular cartilage systems. J. Biomed. Mater. Res. 2009, 90B, 752–759. [Google Scholar] [CrossRef] [PubMed]
- Gustafson, C.T.; Boakye-Agyeman, F.; Brinkman, C.L.; Reid, J.M.; Patel, R.; Bajzer, Z.; Dadsetan, M.; Yaszemski, M.J. Controlled delivery of vancomycin via charged hydrogels. PLoS ONE 2016, 11, e0146401. [Google Scholar] [CrossRef] [PubMed]
- Frisch, M.J.; Trucks, G.W.; Schlege, H.B.; Scuseria, G.E.; Robb, M.A.; Cheeseman, J.R.; Scalmani, G.; Barone, V.; Petersson, G.A.; Nakatsuji, H.; et al. Gaussian 09; Revision A.02; Gaussian, Inc.: Wallingford, CT, USA, 2016. [Google Scholar]
- Cossi, M.; Barone, V.; Cammi, R.; Tomasi, J. Ab initio study of solvated molecules: A new implementation of the polarizable continuum model. Chem. Phys. Lett. 1996, 255, 327–335. [Google Scholar] [CrossRef]
- Brown, D.F.; Kothari, D. Comparison of antibiotic discs from different sources. J. Clin. Pathol. 1975, 28, 779–783. [Google Scholar] [CrossRef]
- Bauer, A.W. Single-disk antibiotic-sensitivity testing of staphylococci: An analysis of technique and results. AMA Arch. Intern. Med. 1959, 104, 208. [Google Scholar] [CrossRef]
- Dutta, D.; Willcox, M. A laboratory assessment of factors that affect bacterial adhesion to contact lenses. Biology 2013, 2, 1268–1281. [Google Scholar] [CrossRef]
- Lima, M.; Teixeira-Santos, R.; Gomes, L.C.; Faria, S.I.; Valcarcel, J.; Vázquez, J.A.; Cerqueira, M.A.; Pastrana, L.; Bourbon, A.I.; Mergulhão, F.J. Development of chitosan-based surfaces to prevent single- and dual-species biofilms of staphylococcus aureus and pseudomonas aeruginosa. Molecules 2021, 26, 4378. [Google Scholar] [CrossRef]
- Technical Committee. ISO/TC 194 part 12: Preparation of samples and reference materials. In ISO 10993-5:2009 Biological Evaluation of Medical Devices; British Standards Institution: London, UK, 2009. [Google Scholar]
- Peinado, C.; Salvador, E.F.; Corrales, T.; Bosch, P.; Catalina, F. Fluorescent probes for monitoring the pulsed-laser-induced photocuring of poly(urethane acrylate)-based adhesives: Fluorescent probes. J. Polym. Sci. Part A Polym. Chem. 2004, 42, 1227–1238. [Google Scholar] [CrossRef]
- Scherzer, T.; Decker, U. Real-time FTIR–ATR spectroscopy to study the kinetics of ultrafast photopolymerization reactions induced by monochromatic UV light. Vib. Spectrosc. 1999, 19, 385–398. [Google Scholar] [CrossRef]
- Paczkowski, J.; Neckers, D.C. New fluorescence probes for monitoring the kinetics of laser-initiated polymerization. J. Polym. Sci. Part A Polym. Chem. 1993, 31, 841–846. [Google Scholar] [CrossRef]
- Liu, M.; Li, M.-D.; Xue, J.; Phillips, D.L. Time-resolved spectroscopic and density functional theory study of the photochemistry of irgacure-2959 in an aqueous solution. J. Phys. Chem. A 2014, 118, 8701–8707. [Google Scholar] [CrossRef] [PubMed]
- Kim, S.W.; Bae, Y.H.; Okano, T. Hydrogels: Swelling, drug loading, and release. Pharm. Res. 1992, 9, 283–290. [Google Scholar] [CrossRef]
- Rosu, D.; Rosu, L.; Cascaval, C.N. IR-change and yellowing of polyurethane as a result of UV irradiation. Polym. Degrad. Stab. 2009, 94, 591–596. [Google Scholar] [CrossRef]
- Marchioli, G.; Zellner, L.; Oliveira, C.; Engelse, M.; de Koning, E.; Mano, J.; Karperien; van Apeldoorn, A.; Moroni, L. Layered PEGDA hydrogel for islet of langerhans encapsulation and improvement of vascularization. J. Mater. Sci. Mater. Med. 2017, 28, 195. [Google Scholar] [CrossRef] [PubMed]
- Liu, S.; Yeo, D.C.; Wiraja, C.; Tey, H.L.; Mrksich, M.; Xu, C. Peptide delivery with poly(ethylene glycol) diacrylate microneedles through swelling effect. Bioeng. Transl. Med. 2017, 2, 258–267. [Google Scholar] [CrossRef] [PubMed]
- Allen, G. Comprehensive Polymer Science and Supplements; Elsevier: New York, NY, USA, 1996; ISBN 978-0-08-096701-1. [Google Scholar]
- Berlman, I. Handbook of Fluorescence Spectra of Aromatic Molecules; Academic Press: New York, NY, USA, 1965. [Google Scholar]
- Ware, W.R. Oxygen quenching of fluorescence in solution: An experimental study of the diffusion process. J. Phys. Chem. 1962, 66, 455–458. [Google Scholar] [CrossRef]
- Hintermann, L. Comprehensive organic name reactions and reagents. Angew. Chem. Int. Ed. 2010, 49, 2659–2660. [Google Scholar] [CrossRef]
- Andrzejewska, E. Photopolymerization kinetics of multifunctional monomers. Prog. Polym. Sci. 2001, 26, 605–665. [Google Scholar] [CrossRef]
- Akram, N.; Mansha, A.; Premkumar, R.; Benial, A.M.F.; Usman, M.; Rasool, N.; Asim, S. Spectroscopic, quantum chemical and molecular docking studies of 2-Hydroxy-4′-(2-hydroxyethoxy)-2-methylpropiophenone: A potent anti-Alzheimer’s drug. Chem. Data Collect. 2020, 29, 100495. [Google Scholar] [CrossRef]
- Ma, Z.; Niu, X.; Xu, Z.; Guo, J. Synthesis of novel macrophotoinitiator for the photopolymerization of acrylate. J. Appl. Polym. Sci. 2014, 131, 40352. [Google Scholar] [CrossRef]
- Atkins, P.W.; De Paula, J. Elements of Physical Chemistry, 5th ed.; Oxford University Press: Oxford, UK; New York, NY, USA, 2009; ISBN 978-1-4292-1813-9. [Google Scholar]
- Schneider, C.A.; Rasband, W.S.; Eliceiri, K.W. NIH Image to ImageJ: 25 years of image analysis. Nat. Methods 2012, 9, 671–675. [Google Scholar] [CrossRef]
- Technical Committee. ISO/TC 194 part 5: Tests for in vitro cytotoxicity. In ISO 10993-5:2009 Biological Evaluation of Medical Devices; British Standards Institution: London, UK, 2009. [Google Scholar]

Publisher’s Note: MDPI stays neutral with regard to jurisdictional claims in published maps and institutional affiliations. |
© 2022 by the authors. Licensee MDPI, Basel, Switzerland. This article is an open access article distributed under the terms and conditions of the Creative Commons Attribution (CC BY) license (https://creativecommons.org/licenses/by/4.0/).
Share and Cite
Tozar, T.; Nistorescu, S.; Boni, M.; Gradisteanu Pircalabioru, G.; Negut, I.; Staicu, A. Pulsed Laser Photo-Crosslinking of Gelatin Methacryloyl Hydrogels for the Controlled Delivery of Chlorpromazine to Combat Antimicrobial Resistance. Pharmaceutics 2022, 14, 2121. https://doi.org/10.3390/pharmaceutics14102121
Tozar T, Nistorescu S, Boni M, Gradisteanu Pircalabioru G, Negut I, Staicu A. Pulsed Laser Photo-Crosslinking of Gelatin Methacryloyl Hydrogels for the Controlled Delivery of Chlorpromazine to Combat Antimicrobial Resistance. Pharmaceutics. 2022; 14(10):2121. https://doi.org/10.3390/pharmaceutics14102121
Chicago/Turabian StyleTozar, Tatiana, Simona Nistorescu, Mihai Boni, Gratiela Gradisteanu Pircalabioru, Irina Negut, and Angela Staicu. 2022. "Pulsed Laser Photo-Crosslinking of Gelatin Methacryloyl Hydrogels for the Controlled Delivery of Chlorpromazine to Combat Antimicrobial Resistance" Pharmaceutics 14, no. 10: 2121. https://doi.org/10.3390/pharmaceutics14102121
APA StyleTozar, T., Nistorescu, S., Boni, M., Gradisteanu Pircalabioru, G., Negut, I., & Staicu, A. (2022). Pulsed Laser Photo-Crosslinking of Gelatin Methacryloyl Hydrogels for the Controlled Delivery of Chlorpromazine to Combat Antimicrobial Resistance. Pharmaceutics, 14(10), 2121. https://doi.org/10.3390/pharmaceutics14102121

